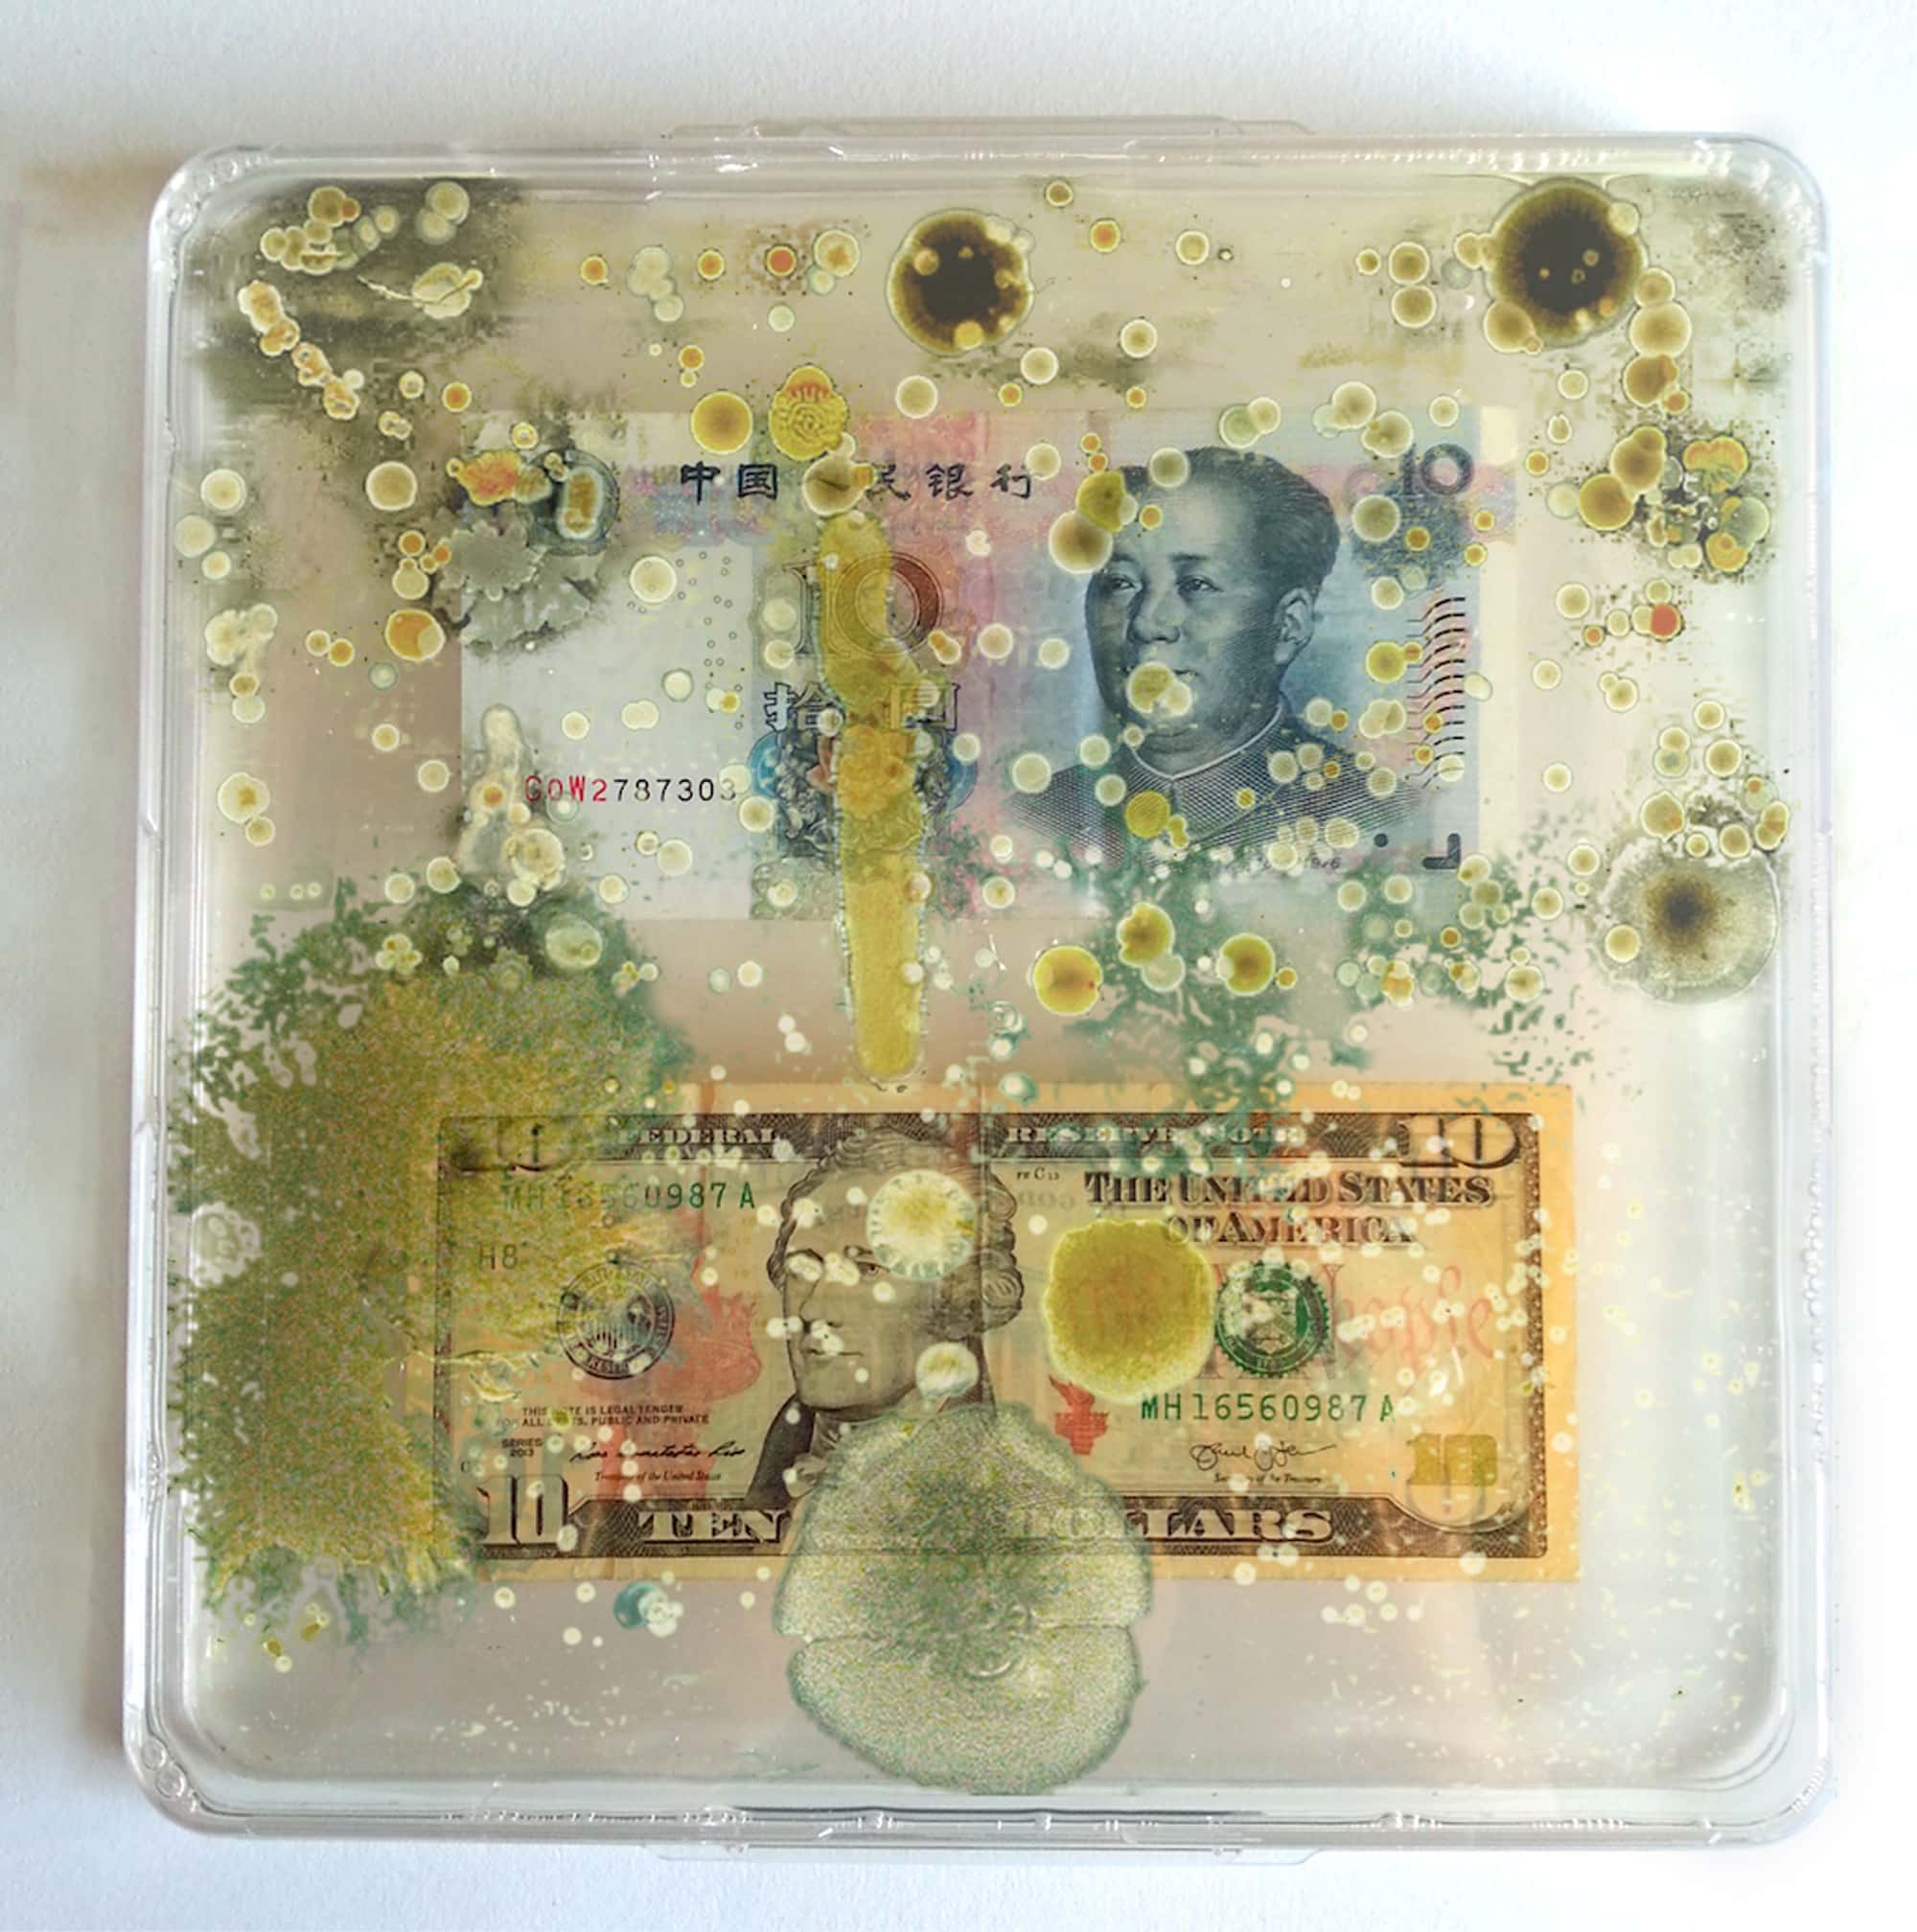

Borderless Bacteria / Colonialist Cash
Ken Rinaldo
Borderless Bacteria / Colonialist Cash discusses important current aspects of biopolitics. By visualising microbiome landscapes of banknotes, the project invites us to reflect about the interconnectedness of ecological and economic exchanges. Wishing to lessen his carbon footprint, artist Ken Rinaldo expressed the wish that the work be made without his travelling. This work was first done during a residency in 2017 at Cultivamos Cultura, Portugal. Some of the works in the exhibition were created in December 2019 with students from the Gustav-Freytag-Schule in Berlin-Reinickendorf as part of a collaboration between the school, ALB and the DIY Hack the Panke collective.
Much recent attention has been given to the human microbiome, the microbes which live on and within our bodies. These communities also exist on most surfaces around us. When we touch objects, we exchange bacteria, fungi and viruses, leaving some microbiota behind. It is no surprise that one of the objects we touch most – money – is not only a medium of economic but also microbial exchange. According to a study conducted by the NYU Center for Genomics & Systems Biology, 3000 types of bacteria were identified on dollar bills from just one Manhattan bank.
Ken Rinaldo, an established artist in the field of Bio and Postmedia art, develops hybrid human-nonhuman ecologies. Borderless Bacteria / Colonialist Cash explores the hidden microbiome of money within a critical framework that also sheds light on exchange and power. Do Chinese Yuan and American Dollars share bacterial and fungal communities?
This micro-performative project is intriguingly simple in its set-up: Various bills of international currency are displayed in large square Petri dishes on enriched agar. Time plays a crucial role, as a microbial landscape grows and realises itself over the course of several weeks. Visitors to the exhibition can also explore the developing Petri dishes with the aid of light boxes and a digital microscope.
On an aesthetic level, the iconography of the currency literally loses face as microbial growth undermines the representational aspect of the banknotes. The official character of money is subverted. As its microbial nature comes to light, it appears far less representative: a fine network of mycelia covers the head of George Washington on a $1 note; on a 10 CHF note, Le Corbusier is no longer recognisable due to bacterial growth.
Aesthetic and biopolitical aspects are closely linked: We are reminded of the colonial roots of capitalism, when exchanged goods spread smallpox, measles and influenza to aboriginal peoples in the Americas and Australia, devastating local populations. The nonhuman has always played a vital, if untold, role in our histories and the development of our economic and cultural systems. “Paper money microbes don’t respect money or borders and travel freely both enhancing and simultaneously challenging the collective human body, microbiome, constitution, and post-colonial ecologies” remarks Rinaldo. He refers here to both the symbolic memories of a colonialist past that paper money possesses “as well as emerging colonialist presence, driven by both microbes and now psychometrics with data analytics. As money is a potent signifier of identity, nationalism and a symbolic medium of exchange, it also possesses constitutional beliefs in iconic invocations of wealth and national trust. Money implies all the attendant deities and symbols of nationalist power and oversight.”
In the exhibition we offer the recipients an opportunity to interact with the project: By means of a digital microscope one can explore both microscopic landscapes of bacterial and fungal colonies as well as discover up-close the detailed engravings of numerous bank notes. While observing the micro world of currencies, one can simultaneously reflect the macro connections between them on economic and biopolitical levels.
Regine Rapp and Christian de Lutz (curators)
Thanks to Marta De Menezes and Dr Luís Graça, Cultivamos Cultura; Dr. Mario Ramirez, Molecular Microbiology & Infection, Instituto de Medicina Molecular in Lisbon, Portugal; Prof. Amy Youngs; Dr. Adam Zaretsky.